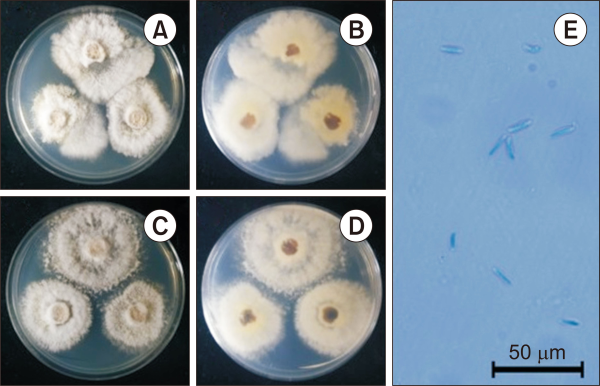
pnie-3-3-172-f1.jpg
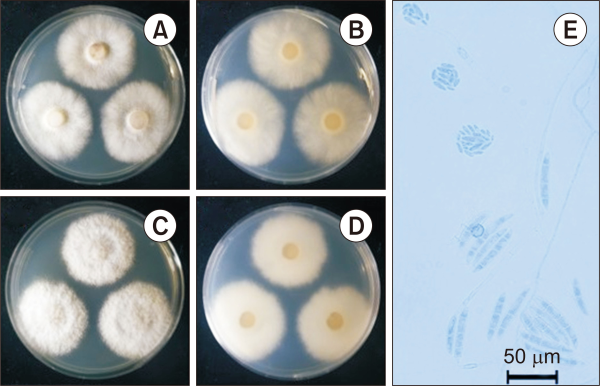
pnie-3-3-172-f2.jpg

Introduction
Fungi can secrete many kinds of enzymes to decompose organic materials and absorb sugars and low molecular weight substances to use them for their metabolism. Since any substances can be used for them, they can be live everywhere on Earth and be found as a major component in any biota (Watkinson et al., 2015). In particular, fungi in the soil are closely related to their surrounding organisms and the environment, so they react quickly to changes in that environment. Therefore, they are also effective biomarkers for changes in soil conditions (Martinez-Salgado et al., 2010). In addition, a wide variety of soil fungi have high biodiversity worldwide. Soil fungi play various roles such as allowing plants to resist pathogens or promoting plant growth by helping the to absorb the nutrients in the soil (Martinez-Salgado et al., 2010; Sikes et al., 2009).
Dokdo is a volcanic island located at the easternmost point of the Korean peninsula that was formed by Cenozoic volcanic activity. Dokdo consists of Dongdo (eastern island), Seodo (western island), and annexed islets. It is a designated natural reserve to protect its natural resources and landscape along with Mt. Halla and Mt. Seorak (Jeon, 2005). Most of the island has steep slopes with shallow soil layers of about 0-20 cm (Jeon, 2005; Sonn et al., 2011). Due to these shallow soil layers and oceanic climate, the plant diversity of Dokdo differs from the mainland Korean peninsula, so several studies and regular surveys have focused on and been conducted on the flora of Dokdo (Lee et al., 2007; Park et al., 2010). However, fungal research in Dokdo soil is very scarce, and only few papers about the Macrofungi (Xylodon flaviporus) and microfungi (arbuscular mycorrhizal fungi) that symbiose with plants through the roots have been published (Eo et al., 2017; Jo et al., 2019).
The National Institute of Ecology (NIE) conducted a 『2020 Ecosystem Survey of Dokdo Island』 to confirm the biodiversity of Dokdo due to its geological characteristics and oceanic climate. Through this 2020 fungal survey of Dokdo, Diaporthe perseae and Fusarium falciforme were discovered, and these were confirmed unrecorded fungal species in Korea based on its morphological and molecular characteristics and so are reported here.
Materials|Methods
Isolation of soil fungi
The soil samples used for the study were collected from Dokdo (Seodo), located in Ulleung-gun, Gyeongsangbuk-do of Korea in September 2020. The collected soil samples were stored in zipper bags until the fungi were isolated and then transferred to the laboratory (4°C). For serial dilution of fungi, samples were serially diluted 10-3, and then 100 μL of each sample was spread on potato dextrose agar (PDA, MBcell, Seoul, Korea) and incubated for 2-3 days at 25°C (Das et al., 2018). Soil fungi grown on PDA medium were sub-cultured on PDA medium to obtain pure isolates. Fungi were cultured in the dark at 25°C and morphological characteristics of the colonies were observed after cultivation on PDA and maltose extract agar (MEA, MBcell). Microstructures were observed after staining with lactophenol under an optical microscope (DM2500; Leica Microsystems, Wetzlar, Germany). Unrecorded soil fungi in this study were deposited with the Korean Collection for Type Cultures.
DNA analysis of soil fungi
Fungal genomic DNA was extracted using a plant tissue genomic DNA extraction kit (Xiʼan Tianlong Science & Technology, Shaanxi, Taiwan) following the manufacturer’s instructions. In performing polymerase chain reaction (PCR), fungal genomic DNA was amplified from internal transcribed spacer (ITS) region including 5.8S ribosomal DNA using ITS1 and ITS4 primers and the translation elongation factor 1-α (TEF1-α) region using EF1-526F and EF1-1567R primers. PCR amplification of ITS region was performed under the following condition; 94°C for 5 minutes, followed by 30 cycles of 94°C for 30 seconds, 50°C for 30 seconds, 72°C for 1 minutes, and a final extension at 72°C for 5 minutes. And TEF1-α region was performed under the following condition; 95°C for 8 minutes, followed by 30 cycles of 95°C for 15 seconds, 58°C for 20 seconds, 72°C for 30 seconds, and a final extension at 72°C for 5 minutes (Rehner & Buckley, 2005; Vilgalys & Hester, 1990; White et al., 1990). The PCR products were electrophoresed on a 1.5% agarose gel to confirm the amplified DNA fragments and the PCR products were sequenced at Macrogen (Seoul, Korea).
To identify the fungal species, the nucleotide sequence was analyzed and compared to the reference nucleotide sequence using Basic Local Alignment Search Tool from the National Center for Biotechnology Information. A neighbor-joining tree was generated by MEGA X based on the Kimura-2 parameter distance model with the 1,000-times bootstrap method (Kumar et al., 2018).
Results|Discussion
Diaporthe perseae (Zerova) R.R. Gomes, Glienke & Crous, Persoonia 31: 29 (2013) [MB#802944]
The colony diameter after seven days was 320.1-508.8 mm on MEA and 246.2-334.1 mm on PDA. The mycelium was rather dense. The marginal part of the colony maintained a somewhat circular shape in the MEA but showed an irregular shape in the PDA. The surface color was gambogeish-gray (Munsell color notation: 2.5Y 7/2) in MEA and tangeloish-gray (Munsell color notation: 5Y 9/2) in PDA, it had a similar texture to downy hair and there was no exudate. The reverse was brownish-gray (Munsell color notation: 10Y 8/2) in MEA, and amberish-gray (Munsell color notation: 10Y 8/2) in PDA (Munsell Color, 2012).
Under a light microscope, only alpha conidia were identified. Alpha conidia measured about 10.5-14.8 μm×2.1-3.9 µm (n=20) and were blunt rods with round ends. The color of the spores was transparent, stained blue under lactophenol cotton blue, and showed no septa inside (Fig. 1 and Table 1) (Dong et al., 2021).
Specimen examined: Dokdo (Seodo), Gyeongsangbuk-do, Korea, 37°14'33.7''N, 131°51'51.5''E, 2020.9.12., isolated from soil taken from Dokdo, strain NIE32018, GenBank no. OL614769 (ITS) and TEF1-α submitting (grp8312890).
Fusarium falciforme (Carrión) Summerb. & Schroers, J. Clin. Microbiol. 40(8): 2872 (2002) [MB#483950]
The colony diameter after seven days was 379.5-409.2 mm on MEA and 364.9-443.8 mm on PDA. The mycelium was rather dense. The marginal part of the colony maintained a more or less regular circular shape. The surface color was light vermilionish-gray (Munsell color notation: 2.5Y 9/2) in MEA, light amberish-gray (Munsell color notation: 7.5Y 9/2) in PDA, had a texture similar to down or cotton, and air hyphae were developed on the surface of the curly (MEA) or linear (PDA), and there was no exudate. The reverse was light gambogeish-gray (Munsell color notation: 5Y 9/2) in MEA, and amberish-gray (Munsell color notation: 10Y 8/2) in PDA (Munsell Color, 2012). Under a light microscope, macroconidia measured about 43.5-71.3 µm×8.0-11.3 µm (n=20) and pointed to a falcate shape. The color of the spores was transparent, stained blue under lactophenol cotton blue, and showed 3-4 septa inside. Microconidia measured about 8.0-13.2 µm×2.6-5.9 µm (n=20) and were rhabdomeric-shaped, round and blunt, tapering toward both ends. The color of the spores was transparent, stained blue under lactophenol cotton blue, and showed no septa inside (Fig. 2 and Table 2) (Carrion, 1951; Vega-Gutiérrez et al., 2019).
Specimen examined: Dokdo (Seodo), Gyeongsangbuk-do, Korea, 37°14'27.9''N, 131°51'52.3''E, 2020.9.12., isolated from soil of Dokdo, strain NIE32043, GenBank no. OL614487 (ITS) and TEF1-α submitting (grp8312890).
Figs. 3 and 4 show the results of phylogenetic analysis using ITS and TEF1-α of the unrecorded soil fungi Diaporthe perseae and Fusarium falciforme identified in this study (Figs. 3, 4). As a result, the nucleotide sequences of Diaporthe perseae and Fusarium falciforme found in Dokdo formed a group with the reference sequence.
Diaporthe perseae was first reported by Zerova as an asexual generation, Phomopsis, in 1940. Then, Gomes reclassified Diaporthe phylogenetically based on a sexual generation in 2013 (Gomes et al., 2013; Zerova, 1940). Diaporthe spp. belong to the family Diaporthaceae and are found in all parts of the host plant, from roots to fruits and stems. Many species in the genus Diaporthe are found not only as endophytes but also exhibiting pathogenic properties (Gomes et al., 2013). As such, Diaporthe spp. can become an endophyte to pathogen depending on the genetic type, environmental condition, and host plants (Schulz & Boyle, 2005). For example, endophytic fungi without pathogenicity can be converted into pathogens according to the aging of the host plant (Saikkonen et al., 1998). Diaporthe perseae collected in this study was isolated from the rhizosphere soil of Artemisia japonica ssp. littoricola (Kitam.) Kitam. in Seodo. According to previous studies, Diaporthe spp. were found as an endophytic fungi in about 11 species of Artemisia (Cosoveanu & Cabrera, 2018). Considering that Diaporthe is closely related to plants, A. japonica ssp. littoricola might be considered as a host plant associated with this fungus.
Fusarium falciforme was first reported by Carrión in 1951 and was reported as Cephalosporium falciforme at the time of the report. The genus Fusarium is widely distributed in the soil and most have been reported as plant pathogens and saprophytic fungi (Nelson et al., 1994). Fusarium falciforme collected in this study was isolated from the rhizosphere soil of Festuca rubra L. in Seodo. It is necessary to research the phytopathogenecity of individual Fusarium species in root, stem, fruit, etc. (Duarte et al., 2019).
To date, the biodiversity of fungi is thought to include >1.5 million species (Arnold, 2007). However, <100,000 species have been reported and recorded so far (Petersen, 2013). In Korea, about 4,141 species have been identified and published according to the National List of Species of Korea in 2015 (Y. Lee et al., 2015; Y.S. Lee et al., 2015). These numbers are far below the results of overseas surveys and estimated biodiversity and is thought to be a result of focusing on the excavation of mushrooms, including Basidiomycetes.
Fungi can perform various ecological functions such as symbionts and decomposers and can be distributed in various ways according to their ecological status (Yuan et al., 2011). Therefore, as in this study, it will be necessary to identify fungi according to the type of ecosystem through investigation and monitoring of unexcavated ecosystems such as remote island areas or caves etc. that have not yet been extensively investigated. Specially, Dokdo have some places with little or no artificial interference by human and as A. japonica ssp. littoricola, there are more than 20 plants that can represent the environment of Dokdo (Ministry of Environment, National Institute of Ecology, 2016). Thus, it is likely that there are other unrecorded fungal species in Dokdo soil, so investigating other survey routes and rhizosphere soils of other plants will reveal more unrecorded fungal species. This strategy is expected to help identify biodiversity of fungi based on the ecological principles pursued by the NIE.
Figures and Tables
Fig. 1
Cultural characteristics of Diaporthe perseae NIE32018 isolated from the soil of Dokdo. (A, B) Front and reversed sides of the colony on PDA. (C, D) Front and reversed sides of the colony on MEA. (E) Alpha conidia. Scale bar=50 µm. PDA, potato dextrose agar; MEA, maltose extract agar.
Fig. 2
Cultural characteristics of Fusarium falciforme NIE32043 isolated from the soil of Dokdo. (A, B) Front and reversed sides of the colony on PDA. (C, D) Front and reversed sides of the colony on MEA. (E) Macro and microconidia. Scale bar=50 µm. PDA, potato dextrose agar; MEA, maltose extract agar.
Fig. 3
Phylogenic tree of Diaporthe perseae NIE32018 isolated from the soil of Dokdo. (A) Internal transcribed spacer region including 5.8S ribosomal DNA and (B) translation elongation factor 1-α were used for the sequence analysis to confirm the topological appropriation of the fungal isolates. Valsa mali and Valsa nivea were used as an out-group in each tree, and bootstrap values are shown at the branches (1,000 replicates).

Fig. 4
Phylogenic tree of Fusarium falciforme NIE32043 isolated from the soil of Dokdo. (A) Internal transcribed spacer region including 5.8S ribosomal DNA and (B) translation elongation factor 1-α were used for the sequence analysis to confirm the topological appropriation of the fungal isolates. Neocosmospora rubicola was used as an out-group in each tree, and bootstrap values are shown at the branches (1,000 replicates).

Table 1
Morphological characteristics of Diaporthe perseae NIE32018 isolated from soil of Dokdo
| Characteristic | Strain | ||
|---|---|---|---|
|
|
|||
| Diaporthe perseae NIE32018 | Diaporthe perseae (Gomes et al., 2013) |
Diaporthe perseae (Dong et al., 2021) |
|
| Colony | PDA & MEA, 25°C, 7 days | MEA, 25°C, 14 days | PDA, 25°C, 4 days |
| Color | MEA, Gambogeish-gray; reverse brownish-gray PDA, Tangeloish-gray; reverse amberish-gray |
MEA, surface sienna with patches of umber, reverse umber with patches of sienna PDA, surface dirty white with patches of sienna, reverse sienna with patches of umber OA, ochreous, with patches of dirty white and iron-grey |
PDA, white and later turns pale white, reverse white |
| Size | MEA, 302.1-508.8 mm; PDA, 246.2-334.1 mm in diameter for seven days | No observation | PDA, 85 mm in diameter for four days |
| Shape | Cottony texture, downy hair mycelium, margin irregular | Moderate aerial mycelium | Patches of sienna, age produce umber color patches turning into sienna, filamentous, entire margin |
| Conidia | Alpha conidia hyaline, aseptate, fusoid with subglobtuse ends, 10.5-14.8 μm×2.1-3.9
μm in diameter No observation No observation |
Alpha conidia aseptate, hyaline, smooth, guttulate, fusoid to ellipsoid, tapering
towards both ends, straight, apex subobtuse, base subtruncate, (6-) 7-8 (-9) μm×2
(-2.5) μm Beta conidia spindle-shaped, aseptate, smooth, hyaline, apex acutely rounded, base truncate, tapering from lower third toward the apex, curved, (15-) 22-25 (-28) μm×1.5 (-2) μm Gamma conidia aseptate, hyaline, smooth, ellipsoid-fusoid, apex acutely rounded, base subtruncate, 9-14 μm×1.5-2 μm |
Alpha conidia 5-8 μm×2-3 µm (x=7±1 μm×2±0.2 µm), aseptate, hyaline, smooth, fusoid
to ellipsoid, tapering toward both ends, straight, apex subobtuse, base subtruncate,
with two to four guttules Beta conidia 17-28 μm×1-2 µm (x=24±3×1±0.2 µm), aseptate, hyaline, spindle-shaped, smooth, apex acutely rounded, base truncate No observation |
Table 2
Morphological characteristics of Fusarium falciforme NIE32043 isolated from the soil of Dokdo
| Characteristic | Strain | ||
|---|---|---|---|
|
|
|||
| Fusarium falciforme NIE32043 | Cephalosporium falciforme (Carrion, 1951) | Fusarium falciforme (Vega-Gutiérrez et al., 2019) |
|
| Colony | MEA & PDA, 25°C, seven days | Glucose agar, three weeks | PDA, 25°C, six days |
| Color | MEA, light vermilionish-gray; reverse light gambogeish-gray PDA, light amberish-gray; reverse amberish-gray |
No observation | PDA, white; reverse brown or yellow |
| Size | MEA, 379.5-409.2 mm; PDA, 364.9-443.8 mm in diameter for seven days | No observation | No observation |
| Shape | Cottony texture, aerial mycelium, margin circular | No observation | White-to-cream-colored aerial mycelium |
| Conidia | Macroconidia hyaline, 3-4 septa, falcate, 43.5-71.3 µm×8.0-11.3 μm in diameter Microconidia hyaline, aseptate, fusoid, 8.0-13.2 µm×2.6-5.9 μm in diameter |
Conidia simple, longish oval, curved multicellular, 9-12 µm×3-4 μm diameter, longitude 30 μm | Macroconidia; hyaline, three septa, falciform, 29.5-50.3 µm×5.0-8.1 μm diameter Microconidia; hyaline, unicellular, zero to two septa, oblong, 9.6 µm–14.9×4.0-6.3 µm in diameter |